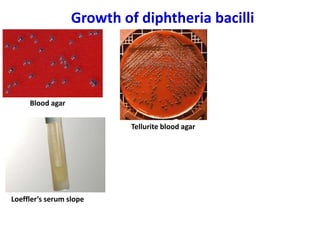
Growth of diphtheria bacilli
Blood agar
Loeffler’s serum slope
Tellurite blood agar

Corynebacterial Toxins
The document discusses Corynebacteria and their toxins, focusing on Corynebacterium diphtheriae, which causes diphtheria. C. diphtheriae produces a potent exotoxin that inhibits protein synthesis and causes tissue damage. The toxin has two components - component A carries the enzymatic activity, while component B binds to host cell receptors to transport component A inside cells. After entering cells, the toxin enzymatically modifies elongation factor 2, blocking protein synthesis and killing host cells. Vaccines containing toxoid have greatly reduced diphtheria incidence worldwide.











![Diphtheria Toxin
• Blocks protein synthesis
• Protein 63Kd
• controlled by Tox gene
• lysogenic phage Beta-corynephage
• Expressed if [iron] low
• 2 components A-B](https://image.slidesharecdn.com/corynebacteriumtoxins-210226184751/85/Corynebacterial-toxins-12-320.jpg)












![Regulation of Diphtheria Toxin High [Fe 2+]
dtxR
Fe 2+ + apo DtxR
[Fe 2+
*DtxR]
p
C diphtheriae
dtxR= repressor protein
NO Toxin Produced
tox
Corynebacteriophage beta
o
P](https://image.slidesharecdn.com/corynebacteriumtoxins-210226184751/85/Corynebacterial-toxins-25-320.jpg)
![Regulation of Diphtheria Toxin Low [Fe 2+]
Fe 2+ + apo DtxR
[Fe 2+
*DtxR]
Toxin Produced!!!
tox
Corynebacteriophage beta
o
P](https://image.slidesharecdn.com/corynebacteriumtoxins-210226184751/85/Corynebacterial-toxins-26-320.jpg)